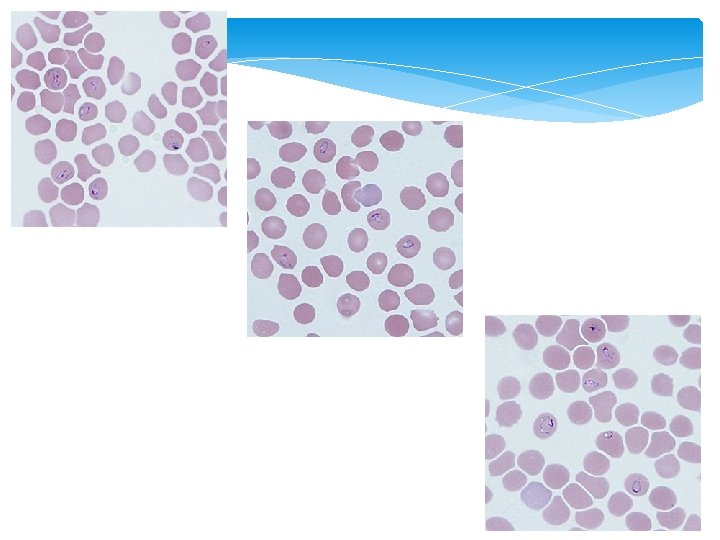

Review of parasitic infections Fungal and parasitic skin

- Slides: 32
Review of parasitic infections Fungal and parasitic skin and soft tissue infections Assoc. Prof. Dr. Yesim Gurol
CASE 1
A 31 -year-old man was admitted to a local hospital with fever, chills, myalgia, and fatigue. His travel history included a two week workrelated trip to Cambodia and a one week vacation in Connecticut immediately after that trip. His symptoms began about 3 days after returning from Connecticut. He indicated that he did take anti-malarial prophylaxis while in Cambodia but failed to take the remainder of his medication before going to Connecticut. Blood smears were ordered, stained with Giemsa, and examined. Figures show what was observed at 1000 x oil magnification. What is your diagnosis? Based on what criteria?
This was a case of babesiosis caused by Babesia sp. Morphologic features included: · pleomorphic and vacuolated intraerythrocytic ring-like parasites in normal-sized red blood cells. · an absence of malarial pigment found in Plasmodium species. In general, identification of Babesia to the species or strain level is not possible by morphology, and requires molecular analysis of a blood specimen. Regrettably, no pretreatment blood was available in this case for subsequent testing so the final diagnosis remains Babesia sp.
CASE 2 A seven year old child was taken to the doctor for abdominal pain, gas, bloating, and intermittent diarrhea. The symptoms started two days after returning from summer camp. Stool specimene were collected for ovaparasite examination. Check the figures and what is the best diagnosis?
This was case of giardiasis caused by Giardia intestinalis. Also present was Chilomastix mesnili, a flagellate generally considered nonpathogenic. Diagnostic morphologic features included: - ovoid cysts of G. İntestinalis ( showing nuclei, axonemes and median bodies. ) - oval to lemon-shaped cysts of C. mesnili (showing a single nucleus and a cytostome running along a lateral edge. - The Chilomastix cysts are slightly smaller than the Giardia cysts.
CASE 3
A 30 -year-old man presented to his primary care provider with abdominal pain, fatigue, and diarrhea (sometimes tinged with blood). The patient had recently returned after two weeks in Armenia. A stool specimen was collected in both 10% formalin and poly-vinyl alcohol (PVA) for routine ova-and-parasite (O&P) examination. A smear was prepared from the PVA-preserved specimen and stained with trichrome. The objects of interest measured on average 25 micrometers in length. What is your diagnosis? Based on what criteria?
This was a case of amebiasis caused by Entamoeba histolytica. Morphologic features shown included: · trophozoites showing ingested red blood cells. · nuclei showing evenly distributed peripheral chromatin and a centrally-located karyosome. · some trophozoites showing progressive pseudopods. If ingested red blood cells are observed, a species-level identification of E. histolytica may be given. Specimens presenting with these morphologic features, but without ingested RBCs, should be reported as E. histolytica/dispar and further testing such as PCR should be performed.
CASE 4
A 27 -year-old male from Cameroon, who immigrated to the U. S. six years ago, presented to his health care provider with ocular pain and swelling. He told his health care provider that he had an episode of "a worm crawling in his eye" three years prior. Upon examination, the man was found to have a worm-like object below the conjunctiva (Figure) and it was removed surgically. Figure B shows the object after it was removed; it measured a little over 4 cm. Figure C shows one end of the object at 40 x magnification. A blood specimen was also collected and thick smears were prepared and stained with Giemsa. What is your diagnosis? Based on what criteria?
This was a case of loiasis caused by Loa loa. Diagnostic features included: • location of the worm in the eye. • the presence of irregularly-spaced bosses on the cuticle • robust microfilaria with a short head space and a tapered tail with nuclei spaced irregularly to the tip of the tail
CASE 5
The patient was 3 year old female. Her mother was an elementary school teacher and on school days the patient attended a day care center. The patient presented with a 3 day history of increasingly severe diarrhea with three episodes of vomiting. In physical examination the child was lethargic and appeared dehydrated. She had a temperature 38 o. C. The child had lost weight since the last visit to the doctor. A stool specimen was collected and reported as watery, no white or red cell was seen in microscopy.
Culture was negative. A modified acid fast stain of fecal specimen is shown. The child’s diarrhae persisted for 1 more week before resolving.
What organism is infecting this patient? What other intestinal pathogens share similar staining characteristics with this organism? What other techniques besides modified acid fast stains are available for detection this organism? How do you think the child acquired this organism? What kind of patients have a risk to be infected with this agent as a chronic diarrhae?
CASE 6
The patient was a 23 year old male with a 3 year history of pain and itching of the toes of both feet and his left palm and fingers. Small red raised lesions were visible on his left fingers. In the past 3 months he had lost the nails from his great toes. He was in good health which included training for triathlons (swimming 1 hour a day, running and biking). He got medications and stopped for some time he got worsened.
Culture of the organism and microscopy is as shown.
Cases in Medical Microbiology and Infectious Diseases, 3 rd edition, ASM
The outstanding clinical diagnostic symptom is intense itching, usually in the interdigital folds and sides of the fingers, buttocks, external genitalia, wrists, and elbows. The uncomplicated lesions appear as short, slightly raised cutaneous burrows. At the end of the burrow, there is frequently a vesicle containing the female mite. The intense pruritus usually leads to excoriation of the skin secondary to scratching, which in turn produces crusts and secondary bacterial infection.